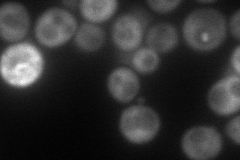
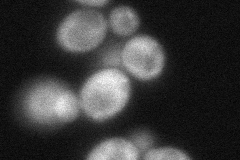
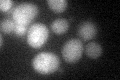

View description
ATP-dependent DEAD (Asp-Glu-Ala-Asp)-box RNA helicase, required for translation initiation of all yeast mRNAs; mutations in human DEAD-box DBY are a frequent cause of male infertility
Localization:
Intensity:
Fold change:
Significance:
-
C’ GFP library in SD

cytosol19.4 -
N' NOP1pr-GFP in SD

cytosol216.144 -
N' TEF2pr-mCherry in SD
cytosol99.2159 -
N' NATIVEpr-GFP in SD

cytosol343.541 -
N' TEF2pr-VC and Cyto-VN in SD
cytosol61.8512 -
C’ GFP library in SD+DTT
cytosol16.490.84No -
C’ GFP library in SD+H2O2

cytosol16.770.86No -
C’ GFP library in Starvation Media

cytosol14.410.74No -
C’ GFP library on the background of Pup2-DaMP

cytosol -
C’ GFP library on the background of CCT mutant

cytosol18.27930.941848No
